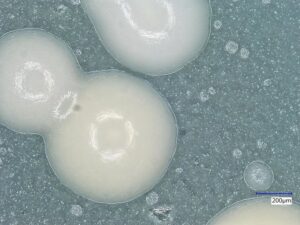

La Cannabis o canapa è un genere di piante a fiore (angiosperma) che costituisce insieme al luppolo (Humulus lupulus) la famiglia delle Cannabaceae, dette anche Cannabinacee.
Alcune varietà della pianta presentano un’elevata percentuale di THCA, il cannabinoide non psicoattivo costituente gran parte del sistema immunitario della pianta il quale, se ingerito e/o sottoposto a temperature maggiori degrada per decarbossilazione nel THC (psicoattivo) e quindi diventando droga. I cannabinoidi sono sostanze chimiche di origine naturale, biochimicamente classificati come terpenofenoli. Sono composti accomunati dalla capacità di interagire con i recettori cannabinoidi del corpo umano e degli altri animali.
La cannabis si divide in 3 specie:
- Cannabis indica (Asia);
- Cannabis sativa (America, Europa);
- Cannabis ruderalis (Siberia, Russia).

PRODOTTI PSICO-ATTIVI DELLA CANNABIS:
- Marijuana (0.5 – 1.5% THC): mistura di prodotti dell’intera pianta;
- Bhang (India) (0.5 – 1.5% THC): mistura di prodotti dell’intera pianta;
- Ganja (2 – 4% THC): mistura resinosa di foglie e fiori;
- Hashish (3 – 7% THC): secrezione resinosa delle infiorescenze;
- Sinsemilla: varietà di marijuana priva di semi;
- Olio di cannabis (20 – 40% THC): concentrato alcoolico.
MODALITA’ DI ASSUNZIONE:
- Inalazione (fumo di sigaretta);
- Infuso o decotto (bhang);
- Ingestione orale (space cake).
Caricamento….


EFFETTI PSICOLOGICI
- Percezioni sensoriali;
- Riferimenti temporo-spaziali;
- Processi mentali;
- Emozioni.
PERCEZIONI SENSORIALI
Con l’uso della cannabis le percezioni sensoriali non vengono alterate, ma vengono intensificate ed in certi casi possono essere interpretate in maniera diversa da quella dello stato di normalità.
Percezioni visive: percezione più acuta di contorni, colori e profondità delle immagini; si può avere l’impressione di forme e significati particolari in immagini visive di oggetti che hanno funzioni del tutto diverse.
Percezione dei suoni: percezione più marcata della separazione spaziale delle fonti sonore; i suoni possono evocare immagini e colori. Viene particolarmente apprezzata la qualità dei suoni.
Percezioni tattili, gustative ed olfattive: vengono esaltate rispetto allo stato normale; tipico è un aumentato apprezzamento dei cibi, collegato all’effetto antiemetico e stimolante dell’appetito.
Attenzione:
La modifica delle percezioni sensoriali si concretizza in una attenzione che è aumentata di intensità ma con un minore raggio di estensione; ne deriva una maggiore concentrazione sul presente e la tendenza ad occuparsi di una sola cosa per volta (ascoltare la musica, parlare).
RIFERIMENTI TEMPORO-SPAZIALI
Possibili le modifiche nella interpretazione delle distanze, che possono apparire più lunghe o più brevi e quindi difficoltà nella guida.
Marcata e tipica la percezione temporale, collegata con la diminuzione dei legami col passato e col futuro; ne deriva una particolare concentrazione in tutto ciò che accade nel momento presente.
PROCESSI MENTALI
- Indebolimento della memoria a breve termine (non ricordare l’inizio della conversazione – alti dosaggi);
- Significati diversi e profondi in situazioni familiari e scontate (ja-mais-vu);
- Tendenza all’introspezione;
- Sensazione di aumento dell’immaginazione (pensieri vaganti, associazioni vivaci, spontanee).
EMOZIONI
La cannabis ha un effetto positivo sull’umore determinando rilassamento, serenità, tendenza al ridere (consumatori occasionali) le emozioni possono essere amplificate, ma anche in senso negativo.
EFFETTI COMPORTAMENTALI
INTEGRAZIONE SOCIALE
- la cannabis ha un effetto disintegratore sui ruoli sociali imposti dalle convenzioni con una minore disponibilità a rispettare le regole ed i rapporti formali;
- diminuzione dell’aggressività;
- maggiore solidarietà di gruppo (superamento delle inibizioni in rapporto al modo di comunicare con gli altri);
- intensificazione dei rapporti con gli altri sia in senso positivo che in senso negativo;
SESSUALITA’
La cannabis non ha un effetto afrodisiaco cioè di eccitazione diretta sulla sfera sessuale ed ad alte dosi può avere un effetto deprimente (come avviene per l’alcool):
- la durata e la qualità dell’atto sessuale tende ad aumentare;
- il desiderio del partner abituale viene aumentato (in misura minore anche di un partner occasionale);
- aumento degli effetti sensoriali (tatto e sensazione di intimità fisica).

GUIDA DI VEICOLI
Gli effetti farmacologici della cannabis ne rendono sconsigliabile il suo uso durante la guida dei veicoli.
La tendenza ad una minore aggressività prodotta dalla cannabis induce ad una minore velocità di guida, al contrario dell’alcool il cui uso determina un aumento dei tempi di reazione ed una maggiore aggressività con tendenza all’aumento della velocità.
GATEWAY THEORY – TEORIA DEL CANCELLO APERTO
I cannabinoidi sono induttivi all’uso di sostanze più pericolose secondo la scala di Guttman che descrive la iniziazione a tappe della tossicodipendenza.

SINDROME AMOTIVAZIONALE (consumatori cronici)
- apatia, tristezza;
- compromissione della memoria;
- perdita di interesse e motivazioni verso il raggiungimento di scopi ed obbiettivi particolari (abbandono della scuola);
- disinteresse per il proprio aspetto e per la cura della persona;
- l’individuo tende a basare la propria vita in funzione di una sopravvivenza minima (lavorare per vivere) e della possibilità di assumere cannabinoidi.
Tolleranza: ±
Dipendenza Fisica: ±
Dipendenza psichica: ++